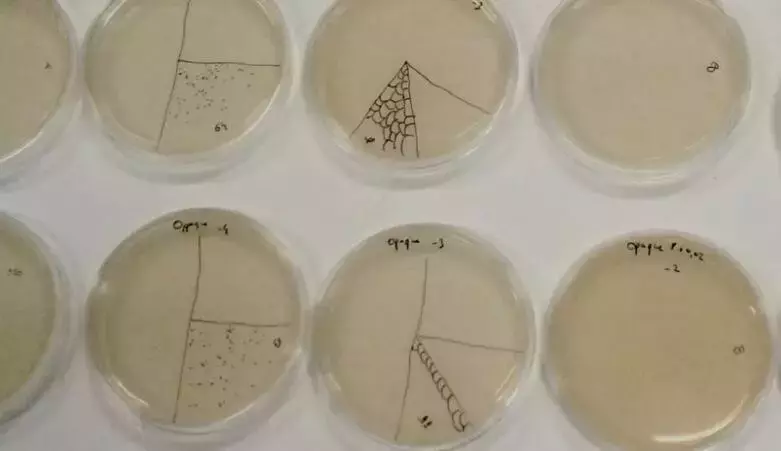
性感模特的皮衣是蘑菇做的?新加坡用树叶做面料?太颠覆啦

性感模特的皮衣是蘑菇做的?新加坡用树叶做面料?太颠覆啦
性感模特的皮衣是蘑菇做的?新加坡用树叶做面料?太颠覆啦!
想过那些机车美女...性感又充满野性美的女模特身上的皮衣...
是蘑菇做的吗?


(图:来源自网络)
据《每日邮报》消息,有科学家开发出一种由真菌制成的纯素皮革,其外观和手感都与真皮别无二致。
这种素皮革由位于旧金山的生物材料公司MycoWorks创造,素皮革由菌丝体制成——即在真菌上发现的管状细丝。MycoWorks公司与专业的传统皮革工匠密切合作,能把纯素皮革做得像真皮一样。


(图:来源自网络)
这种新材料比真正的(动物)皮革更符合道德规范,对环境的影响也更小。使用菌丝体制成的服装是可生物降解的,有望制止“快速时尚”对环境带来的破坏。
菌丝体是真菌的无限可再生根部结构,而蘑菇是真菌的“果实”。通过对低成本的农业和林业副产品(如锯末)进行升级改造,可以用真菌来生产皮革。而菌丝体生长的饲料(一团细长的真菌线),它们会长成片状,几周内就可以收获真菌生物质。
公司还表示,其精细菌丝体(Fine Mycelium)专利技术复制了真皮皮革的外观和手感,同时在强度和耐久性方面优于真皮。



(图:来源自网络)
以往的真皮,都是由动物制成的,通常来自牛、绵羊、羔羊、山羊、马、水牛、猪,甚至海豹、鲸鱼和鳄鱼等水生动物。这些动物制成的皮革引发了道德问题,以及可能造成畜牧业相关的森林砍伐和温室气体排放,给环境带来危害。
素食的思想流派不仅适用于无动物饮食,还适用于服装和家具,或任何可能涉及动物试验的东西。
新加坡也有不少人加入了环保面料革命的生力军。
60岁的许光裕两年前创办Nextevo环保面料公司,在印度尼西亚、泰国和新加坡有三家公司,专把农业废弃的黄梨叶加工处理,变成纺织面料。
(图:来源自网络)
许光裕初时在汽车与重工机械业长达20几年,后来在黄梨种植业担任总裁近10年。他离职后,一度想进入生物质行业,后来跟椰子和香蕉业同行聊起,发现原来这么多被丢弃或烧掉的种植废料都是能再生成面料的宝藏。
许光裕跟泰国一家黄梨罐头食品厂合资,直接跟农民购买黄梨叶。他与团队过去两年成功研发将黄梨叶变成纺织面料的程序。
他说:“我们先将黄梨叶切片,萃取出纤维后,进一步去除胶质和风干后就得出像棉花球状的纤维。我们把这纤维球交给第三方,帮我们融入天丝、有机棉等纤维,加强后纺成纱线。取回纱线后,我们才在自己的厂内织成面料。”

(图:来源自网络)
这些环保纯素面料应用功能极大,能制成衣物、鞋、毛巾及装饰家具等。
黄梨纤维所织成的面料柔滑且透气,可媲美棉布,摸上去时手感清凉,更优于棉布。黄梨纤维能吸收和保留颜料,染出的颜色十分漂亮鲜活。
该材料还得到了国际环保纺织协会(OEKO-TEX)的Standard 100认证,证明布料对婴孩皮肤无害。
黄梨叶是黄梨种植业的副产品,不用特地另辟土地和资源来种,这已经很环保。食品商本来只取黄梨,叶子是废弃物。向农民买下弃物,让农民收入增加至少20%,能改善他们的生活。
这真的是多赢!
评论